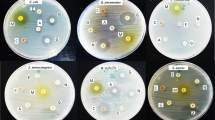

Abstract
IT has been almost twenty years since Osborn1 reported his now classical work on antimicrobial substances from green plants. Since that time the literature accumulated on this subject has been voluminous2. The vascular plants tested, however, have been essentially spermatophytes, with little attention to the pteridophytes. This work is concerned with the extraction of antimicrobial substances from thirty ferns collected at the Brooklyn Botanical Gardens. The specimens were selected at random, and the cut fronds were allowed to dry in air for at least one week before testing. Four additional dried ferns were obtained from other sources and likewise tested.
This is a preview of subscription content, access via your institution
Access options
Subscribe to this journal
Receive 51 print issues and online access
$199.00 per year
only $3.90 per issue
Buy this article
- Purchase on SpringerLink
- Instant access to full article PDF
Prices may be subject to local taxes which are calculated during checkout
Similar content being viewed by others
References
Osborn, E. M., Brit. J. Exp. Pathol., 24, 227 (1943).
Nickell, G. L., Econ. Bot., 13, 281 (1959).
Author information
Authors and Affiliations
Rights and permissions
About this article
Cite this article
MARUZZELLA, J. Antimicrobial Substances from Ferns. Nature 191, 518 (1961). https://doi.org/10.1038/191518a0
Published:
Issue date:
DOI: https://doi.org/10.1038/191518a0
This article is cited by
-
Antibiotic activity of pteridophytes
Economic Botany (1980)
-
Antitumoral Activity of the Fern Cibotium schiedei
Nature (1969)
-
Antibacterial activity of fern extracts
Die Naturwissenschaften (1962)